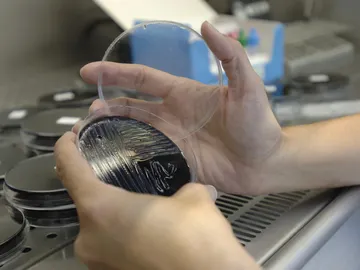
Muestra tomada en una torre de refrigeración Muestra tomada en una torre de refrigeración

Fallece una cuarta persona por el brote de legionela en Manzanares
Asciende a 237 el número de afectados por el brote de legionella
La Fiscalía de Ciudad Real abre diligencias sobre el brote de legionela en Manzanares
La fuente de la estación de autobuses de Manzanares da positivo en legionela

Se eleva a 190 el número de afectados por el brote de legionella en Manzanares

Fallecen dos hombres a causa del brote de legionella en Ciudad Real

Fallece un hombre de 84 años a causa del brote de Legionella en Ciudad Real
Tres detenidos por amenazar con una navaja en un bar para abrir una caja que tenía 10 euros

Catorce heridos en el choque de un tren contra un camión en Ciudad Real

La OTAN desarrolla en España el mayor ejercicio militar colectivo de la última década

Ofrecen hasta 125 millones de euros por el aeropuerto de Ciudad Real
Encuentran en un pozo el cadáver de una mujer en Ciudad Real

Un hombre salva a un buitre leonado desorientado en una carretera

